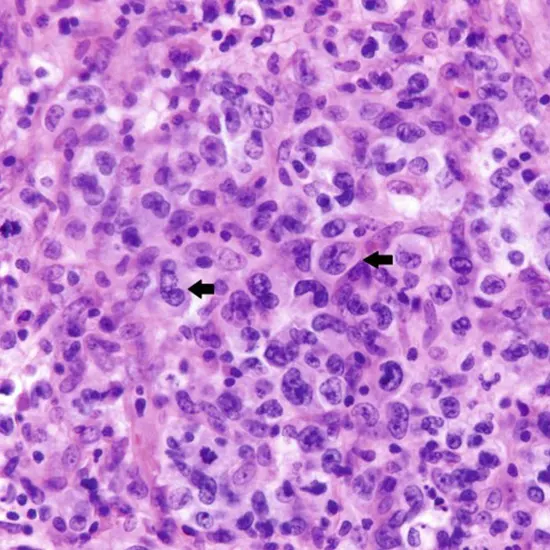

Anaplastic Large Cell Lymphoma (Bone marrow).webp)
Book Alk/NPM1;t(2;5) Anaplastic Large Cell Lymphoma (Bone marrow) Appointment Online Near me at the best price in Delhi/NCR from Ganesh Diagnostic. NABL & NABH Accredited Diagnostic centre and Pathology lab in Delhi offering a wide range of Radiology & Pathology tests. Get Free Ambulance & Free Home Sample collection. 24X7 Hour Open. Call Now at 011-47-444-444 to Book your Alk/NPM1;t(2;5) Anaplastic Large Cell Lymphoma (Bone marrow) at 50% Discount.
Diffuse large B-cell lymphoma in limited stages (stages I and II) has a long-term survival rate of above 90%. (DLBCL). For kids and teenagers with advanced (stage III or IV) DLBCL, the long-term survival rate is between 80% and 90%.
The five-year survival rate of ALK-positive ALCL varies from 33% to 90% depending on factors including your cancer kind and IPI score. ALK-negative ALCL has a survival rate of 13% to 74% after five years.
There may be a treatment for ALCL. The ALK status and the IPI score affect the prognosis. At 5 years, the overall survival (OS) for all patients with ALK-positive ALCL ranges from 70 to 90%, with a failure-free survival (FFS) of about 60%.
What percentage of anaplastic thyroid cancer patients survive? Anaplastic thyroid carcinoma (ATC) has a five to six-month median survival time after diagnosis. One year after being diagnosed with ATC, less than 20% of patients are still alive.
Standard chemotherapy treatments work well to treat ALK-positive ALCL, placing the majority of patients into long-term remission.
Lung cancer that is ALK-positive responds effectively to a class of specific medications known as ALK inhibitors. This malignancy can also be treated with chemotherapy and other medications. But following therapy, it frequently comes back. The stage of lung cancer at diagnosis affects how long a person may have the condition.
The standard first-line treatment for systemic ALCL is still anthracycline-based regimens like cyclophosphamide, doxorubicin, vincristine, and prednisone (CHOP), but in many patients with ALK ALCL, it is ineffective, so consolidative autologous stem cell transplantation is frequently performed afterward.
Stage I: Affected lymph nodes or lymphoid structures are confined to a single area. Stage II: The same side of the diaphragm has two or more afflicted lymph node locations. Stage III - Involvement of the tissues or nodes of the diaphragm.
"Localized" refers to lymphoma that has only spread to one specific part of the body (stage 1 or 2). It is referred to as "advanced" when it is more advanced (stage 3 or 4). More than 70% of kids with anaplastic large cell lymphoma are cured of their illness with the help of modern treatments.
| Test Type | Alk/NPM1;t(2;5) Anaplastic Large Cell Lymphoma (Bone marrow) |
| Includes | Alk/NPM1;t(2;5) Anaplastic Large Cell Lymphoma (Bone marrow) (Pathology Test) |
| Preparation | |
| Reporting | Within 24 hours* |
| Test Price |
₹ 2800
|

Early check ups are always better than delayed ones. Safety, precaution & care is depicted from the several health checkups. Here, we present simple & comprehensive health packages for any kind of testing to ensure the early prescribed treatment to safeguard your health.